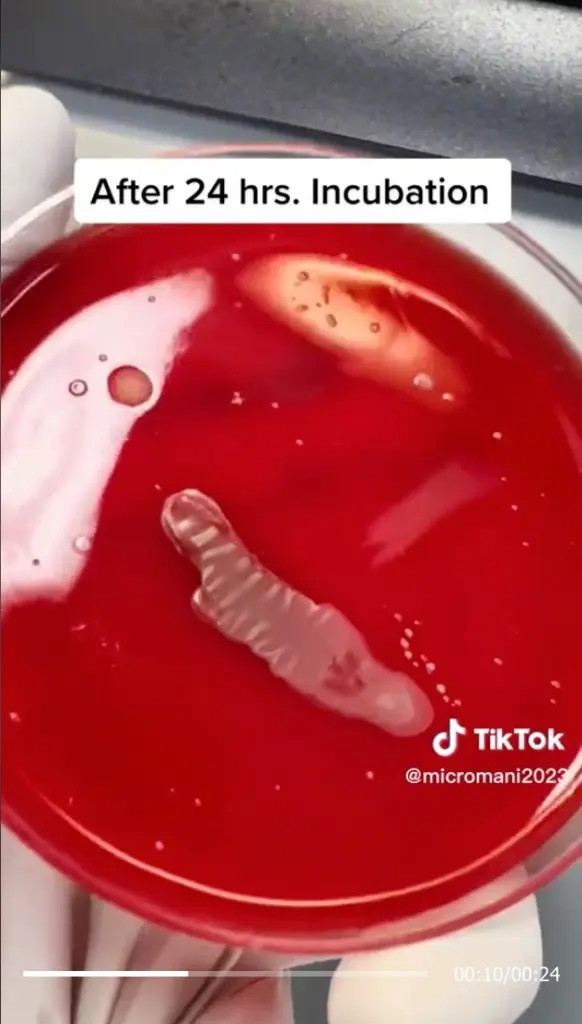
Các thí nghiệm của Abdlrasul được quay video và chia sẻ trên TikTok cho thấy sự phát triển của các vi khuẩn trên các vật dụng sinh hoạt hàng ngày.

![]() |
| Các thí nghiệm của Abdlrasul được quay video và chia sẻ trên TikTok cho thấy sự phát triển của các vi khuẩn trên các vật dụng sinh hoạt hàng ngày. |
Nhà nghiên cứu Amani Abdlrasul làm việc với tư cách là nhà khoa học phòng thí nghiệm y tế ở Tampa, Florida, Mỹ thường chia sẻ kiến thức tổng quát với 60.000 người theo dõi.
Cô đã tiết lộ về những vi khuẩn ẩn nấp trên các vật dụng hàng ngày, chẳng hạn như những vi khuẩn không thể nhìn thấy bằng mắt thường trên tiền giấy, đài phun nước và thậm chí cả bệ ngồi trong nhà vệ sinh.Nhà nghiên cứu này đã thử nghiệm tờ 100 đô la với kết quả đáng báo động.
“Tôi đã đặt tờ 100 đô la lên thạch máu và ủ nó trong 24 giờ. Một số vi khuẩn xuất hiện là Staphylococcus”, cô giải thích trong video đã được xem hơn 1,7 triệu người xem.
Trong một clip đáng báo động khác với 9 triệu lượt xem, nhà nghiên cứu này đã thử nghiệm một bệ ngồi trong nhà vệ sinh công cộng và phát hiện nó có chứa vi khuẩn E. coli đang phát triển.
Trong một lần khác, cô kiểm tra màn hình iPhone của mình và nhận thấy nó chứa nhiều vi khuẩn hơn cô nghĩ ban đầu.
Mặc dù không phải điện thoại của mọi người đều chứa Staphylococcus, nhưng cô khuyên: “Hãy lau sạch điện thoại của bạn, điều này không bao giờ thừa cả”.
Abdlrasul đã sử dụng thạch máu để thực hiện các xét nghiệm của mình. Đây là phương tiện được sử dụng để kiểm tra vi khuẩn hoặc vi khuẩn không dễ phát triển. Cô cho biết, cô muốn sử dụng nền tảng công nghệ để nâng cao nhận thức của mọi người về tầm quan trọng của vệ sinh và sự sạch sẽ nói chung.
Đây không phải là lần đầu tiên một TikToker phát hiện ra những loại vi trùng phổ biến khắp ngôi nhà của bạn.
Đầu năm nay, chuyên gia sức khỏe đường ruột Jordan Haworth đã tiết lộ trên TikTok 10 đồ gia dụng chứa nhiều vi khuẩn nhất hiện đang lan truyền, khẳng định 70% dân số không vệ sinh hàng ngày các đồ vật thường dùng.
Trong một nghiên cứu năm 2015, các nhà nghiên cứu đã tìm thấy hơn 9.000 loài vi khuẩn, vi khuẩn và nấm khác nhau sau khi họ khảo sát hơn 1.200 hộ gia đình.